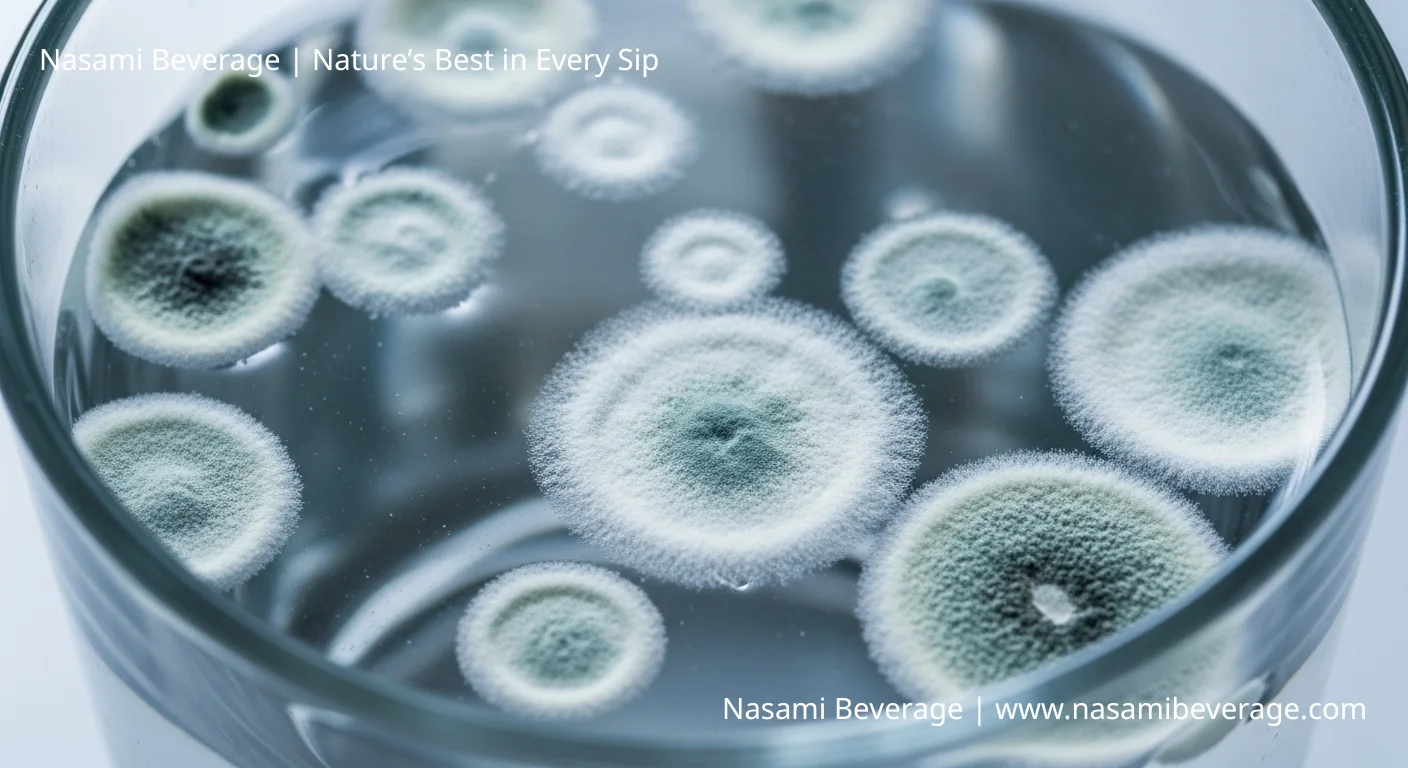
Fresh vs. Spoiled Coconut Water Fresh vs. Spoiled Coconut Water

The tropics demand vigilance. When the heat presses down, few things cut through the humidity like the clear, sweet relief of coconut water.
It is a natural isotonic, a simple truth in a complex world. But this pure elixir, drawn directly from the young fruit, is fragile.
It is alive, and like all living things, it is subject to rot.
Knowing the difference between Fresh vs. Spoiled Coconut Water is not a matter of preference; it is a matter of safety. We pull back the husk on what keeps this hydration safe and when you must turn away.
Disclaimer: This information is for educational purposes only and does not replace professional medical or veterinary advice. Always consult a qualified professional before making decisions related to your health or your pet’s health.

The Two Worlds: From Tree to Tetra Pak
Coconut water exists in two primary states: the immediate, perishable source, and the shelf-stable product engineered for global reach.
Straight from the Husk: The Real Deal
When a machete opens a young green coconut, the water inside is perfect. It is sterile, cool, and immediately consumable. This is the gold standard.
However, once exposed to air-even if refrigerated-this water begins to turn. Natural enzymes and airborne bacteria start the fermentation process quickly.
If you are seeking the absolute purest form, you must also understand how to spot the difference between the good stuff and the rot.
A quick read on how to identify real vs fake coconut water can save you disappointment.

The Shelf-Stable Reality: Processing and Preservation
Most of the coconut water consumed globally-the kind you buy from brands like Vita Coco or Zico-is processed using Ultra High Temperature (UHT) pasteurization.
This heat treatment eliminates pathogens and extends the shelf life to months or even a year, allowing the beverage to be stored in aseptic cartons.
This process sacrifices some delicate flavor notes but ensures safety and stability across continents. The compromise is necessary, but it means the liquid inside the carton is fundamentally different from what comes directly from the tree.

The Tell-Tale Signs of Spoilage
Trust your senses above all else. When assessing whether your drink is Fresh vs. Spoiled Coconut Water, look, smell, and then, perhaps, taste.
Visual Cues: When Clarity Fails
Fresh coconut water is clear, sometimes with a faint, almost translucent opalescence. Any significant deviation is a warning.
- Color Change: If the liquid has taken on a definite hue-such as a deep yellow or brown-it is likely spoiled. While some natural oxidation can cause coconut water turning yellow slightly, a strong color shift indicates significant breakdown.
- Cloudiness and Sediment: Excess cloudiness is a bad sign. While minor, harmless particles (pulp residue) are sometimes present, especially in unpasteurized or less filtered brands (like Amy & Brian), large clumps or floating masses suggest microbial growth. If you see unusual, heavy white flakes in coconut water, discard it.
- Fuzz or Mold: Any visible mold growth, especially around the rim of an opened container, means immediate disposal.

Smell and Taste: The Fermentation Warning
The nose knows. Spoilage begins with fermentation-the conversion of natural sugars into alcohol and acetic acid by yeast and bacteria.
- Acidity and Sourness: Fresh coconut water is mildly sweet and slightly nutty. Spoiled water will taste sharp, sour, or overly acidic.
- The Vinegar Test: A common sign of advanced spoilage is a strong, pungent odor. If the liquid has begun to ferment aggressively, you might ask: does coconut water smell like vinegar? If the answer is yes, the acid content is too high. Do not drink it.

Shelf Life Secrets: Understanding the Timelines
The shelf life of coconut water depends entirely on how it was processed and handled after harvest.
Packaged (Aseptic) vs. Refrigerated (HPP)
| Type of Processing | Shelf Life (Unopened) | Examples | Key Characteristic |
|---|---|---|---|
| Aseptic (UHT) | 6 to 12 months | Vita Coco, Zico, C2O | High heat eliminates pathogens entirely. |
| High Pressure Processing (HPP) | 30 to 60 days | Harmless Harvest | Uses cold pressure; preserves more nutrients but requires refrigeration. |
| Fresh (Unpasteurized) | 2 to 4 days | Local vendors | Highly perishable; must be kept cold. |
Always check the “Best By” date printed on the packaging. For shelf-stable brands like C2O, this date is gospel, assuming the packaging remains intact.
A dented or bulging carton, however, is a sign of internal pressure from spoilage and must be thrown out regardless of the date.

The Open Container Rule
Once the seal is broken, all protective measures cease. Air, bacteria, and temperature become immediate factors.
- Refrigeration is Mandatory: Never leave opened coconut water at room temperature. The clock starts ticking immediately.
- The 24-72 Hour Window: Most manufacturers recommend consuming opened coconut water within 24 hours for best quality, and absolutely no later than 3 days (72 hours), even when stored in a sealed container in the refrigerator.

Safety First: Why You Must Avoid Spoiled Coconut Water
The primary risk of drinking spoiled coconut water is gastrointestinal distress. Once fermentation begins, harmful bacteria, yeasts, and molds can proliferate.
Consuming liquid that has passed the threshold of Fresh vs. Spoiled Coconut Water can lead to:
- Food Poisoning: Symptoms include nausea, vomiting, diarrhea, and abdominal cramps.
- Increased Acidity: The high acetic acid content from fermentation can irritate the stomach lining.
Do not attempt to “test” spoiled water. If there is any doubt-visual, olfactory, or taste-it is not worth the risk. Discard the liquid and reach for a fresh, sealed container of your preferred coconut water.

Frequently Asked Questions (FAQ)
Is pink coconut water safe to drink?
Yes, generally. Pink coconut water is usually a sign of natural oxidation. When certain enzymes in the water are exposed to light and air, they turn pink.
This is particularly common in minimally processed or HPP (High Pressure Processed) brands.
The pink color does not indicate spoilage unless accompanied by sour taste, foul smell, or cloudiness.
How long does packaged coconut water last after opening?
Regardless of the processing method (UHT or HPP), packaged coconut water should be consumed within 24 to 72 hours of opening, provided it is stored continuously in the refrigerator.
After 3 days, the risk of bacterial contamination and fermentation increases significantly.

What are the health risks of drinking spoiled coconut water?
The main health risks are related to food poisoning caused by the ingestion of high levels of bacteria, yeast, or mold that thrive in fermented liquid.
Symptoms typically involve acute gastrointestinal distress, including vomiting, diarrhea, and nausea.

Does unpasteurized coconut water spoil faster than pasteurized?
Absolutely. Unpasteurized coconut water lacks the heat treatment that sterilizes the liquid and kills off natural enzymes.
Therefore, it must be kept refrigerated and typically spoils within 2 to 4 days of harvest, whereas pasteurized (UHT) coconut water remains shelf-stable for months.

The simple act of hydration should not be complicated by risk. Whether you draw your water directly from the husk or rely on the stability of a brand like Harmless Harvest, the rules remain the same: freshness is fragile.
Heed the signs of rot. Trust the expiration date. When in doubt, throw it out. It is the only way to ensure the clear elixir delivers refreshment, not regret.
Follow NasamiBeverage on social media
- Pinterest: pinterest.com/nasamibeveragestz/
- Youtube: @Nasamibeveragecom



